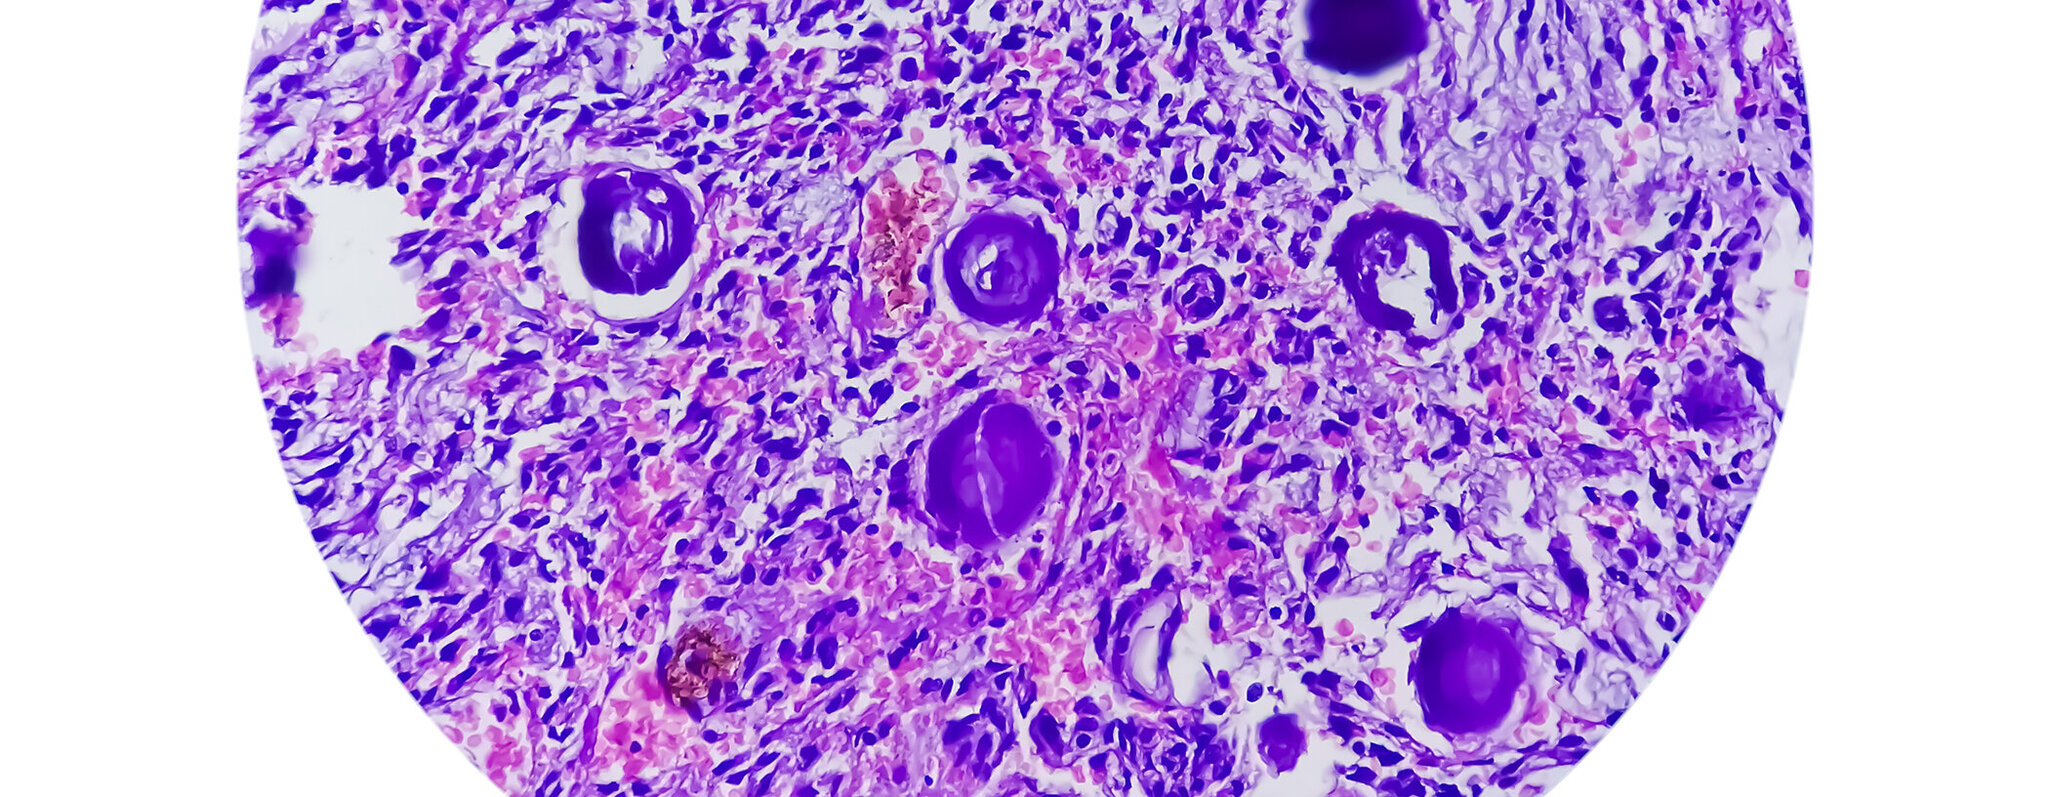

Schwerpunkt Tumororthopädie
Die Tumororthopädie ist eine besonders spezialisierte Fachdisziplin der Klinik für Orthopädie und Orthopädische Chirurgie am UKS. Wir behandeln regional und überregional Patientinnen und Patienten mit den unterschiedlichsten Tumorerkrankungen des Muskel- und Skelettsystems.
Unsere Fachärztinnen und Fachärzte versorgen alle Formen gutartiger und bösartiger Neubildungen des Knochen- und Weichgewebes sowohl konservativ als auch operativ. Wöchentliche Sarkomkonferenzen helfen uns dabei, die hoch spezialisierte Behandlung interdisziplinär zu organisieren und laufend auf dem neuesten Stand der Wissenschaft zu halten.
Was erwartet Sie in der Tumororthopädie am UKS?
Im Fachbereich Tumororthopädie führen wir rund 300 Operationen pro Jahr durch. Das betrifft bösartige und gutartige primäre Neubildungen des Knochen- und Weichgewebes sowie Metastasen. Neben unserer jahrelangen Erfahrung und der außerordentlichen Spezialisierung stellen wir das hohe Niveau durch modernste Technik für unsere Patientinnen und Patienten sicher.
In der Klinik für Orthopädie und Orthopädische Chirurgie am UKS decken wir das gesamte Spektrum der operativen orthopädisch-onkologischen Eingriffe ab. Dazu gehört auch die Entfernung ausgedehnter Tumoren sowie Implantationen von sogenannten Mega-Endoprothesen, die große Segmente von Knochen und umgebenden Geweben ersetzen und damit zum Erhalt von Armen, Beinen, Becken- oder Wirbelsäulensegmenten bei bösartigen Knochentumoren wie Osteosarkom, Chondrosarkom oder Ewing-Sarkom sowie bei Metastasen beitragen.
Für eine ausführliche Beratung, Therapieplanung und -koordination sowie die Nachsorge stehen wir Ihnen mit einer wöchentlichen Sarkomsprechstunde zur Verfügung. Die Terminvereinbarung erfolgt durch die zuweisende Ärztin oder den zuweisenden Arzt.
Formular zur Terminanforderung für Tumorpatienten (PDF)
Ansprechpersonen & Kontakt
Postadresse
Universitätsklinikum des Saarlandes
Klinik für Orthopädie und Orthopädische Chirurgie
Gebäude 37-38
66421 Homburg